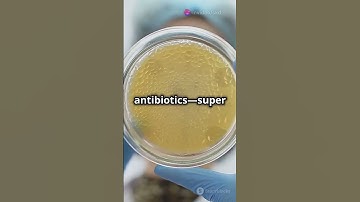
Microbiome vs. Space Radiation: The Mars Mission Challenge! #biology #spacefact #space #spacex

⬇ DOWNLOAD NOW
Jika muncul iklan pop-up, tutup lalu klik tombol kembali
Download lagu Radiation In Space May Change Astronauts' Brain Structure "isn't good for future Mars trip secara gratis hanya untuk keperluan promosi. Dukung artis favorit kamu dengan membeli musik original di iTunes atau platform resmi lainnya.
 Study: Cosmic Rays Could Damage Astronauts' Brains
Study: Cosmic Rays Could Damage Astronauts' Brains Will astronauts travelling to Mars remember much of it?
Will astronauts travelling to Mars remember much of it? Hydrogels The Future of Space Radiation
Hydrogels The Future of Space Radiation Dangerous Space Radiation Poses Threat to Mars Mission Astronauts - NASA Explains
Dangerous Space Radiation Poses Threat to Mars Mission Astronauts - NASA Explains Surviving Deep Space Radiation: The #1 Killer Preventing a Mission to Mars #space #universe
Surviving Deep Space Radiation: The #1 Killer Preventing a Mission to Mars #space #universe Our Stories: "Your Brain on Mars" with Charles Limoli
Our Stories: "Your Brain on Mars" with Charles Limoli Microbiome vs. Space Radiation: The Mars Mission Challenge! #biology #spacefact #space #spacex
Microbiome vs. Space Radiation: The Mars Mission Challenge! #biology #spacefact #space #spacex Surviving Radiation on Mars: Essential Strategies for Future Astronauts
Surviving Radiation on Mars: Essential Strategies for Future Astronauts